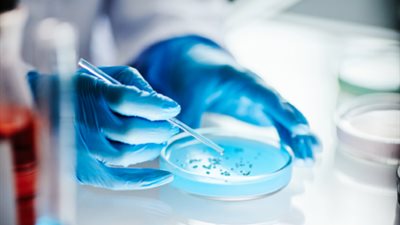
txt

ارتفاع مبيعات السيارات في أوروبا 1.9%

سجلت مبيعات السيارات في أوروبا خلال الشهر الماضي نمواً محدوداً، مدفوعة باستمرار الطلب القوي على السيارات الكهربائية والهجينة.

وأفاد اتحاد مصنعي السيارات الأوروبي، في بيان صدر الأربعاء، أن مبيعات السيارات الجديدة ارتفعت خلال شهر مايو بنسبة 1.9% على أساس سنوي، لتصل إلى 1.11 مليون سيارة، مدعومة بارتفاع المبيعات في أسواق رئيسية مثل ألمانيا وبريطانيا وإسبانيا، في حين تراجعت في فرنسا.
وذكرت وكالة بلومبرغ أن هذا التحسن يأتي في وقت حرج يمر به قطاع صناعة السيارات الأوروبي، الذي يواجه ضعفاً في الطلب المحلي، ومنافسة متصاعدة من الشركات الصينية بقيادة شركة بي.واي.دي، بالإضافة إلى ضغوط سياسية متزايدة لدفع التحول نحو مركبات أقل تلويثاً للبيئة،بحسب الاسواق العربية .
وسجلت مبيعات السيارات الهجينة نمواً ملحوظاً في مايو، حيث ارتفعت مبيعات الطرازات الهجينة القابلة للشحن بنسبة 46% لتتجاوز 100 ألف سيارة، في ظل استمرار المشترين في تفضيل المركبات التي تجمع بين كفاءة البطارية وسهولة التزود بالوقود.
كما شهدت السيارات الهجينة الأخرى نمواً لافتاً، ما يشير إلى استمرار تردد العديد من المستهلكين في التحول الكامل إلى السيارات الكهربائية، في ظل ارتفاع أسعارها المحدود وتفاوت توفر البنية التحتية للشحن الكهربائي.
وقفزت مبيعات السيارات الكهربائية بالكامل (العاملة بالبطاريات) بنسبة 27%، لتبلغ حصتها السوقية 17%، مدفوعة بطرح طرازات جديدة واستمرار الحوافز الحكومية في بعض الدول الأوروبية. ورغم هذا النمو، لا يزال الإقبال على السيارات الكهربائية متفاوتاً بين دول الاتحاد الأوروبي.
تسلا تواصل التراجع
وعلى صعيد الشركات، واصلت شركة تسلا الأميركية تراجعها في السوق الأوروبية، حيث انخفضت مبيعاتها خلال مايو بنسبة 28%، وسط تصاعد المنافسة والجدل السياسي المرتبط برئيسها التنفيذي إيلون ماسك، ما يبدو أنه أثّر سلباً على الطلب.
وفي تطوّر لافت، تساوت مبيعات شركة بي.واي.دي الصينية مع مبيعات تسلا في السوق الأوروبية خلال مايو، بعد أن تجاوزتها لأول مرة في أبريل/نيسان الماضي.
في المقابل، سجلت شركة فولكسفاغن الألمانية ارتفاعاً طفيفاً في مبيعاتها خلال الشهر الماضي، بفضل النسخ المُحدّثة من طرازيها الكهربائيين "آي.دي.4" (SUV) و"آي.دي.7" (الصالون). كما حققت علامتها التابعة سكودا دفعة قوية مع طرح سيارة "إلروك"، وهي سيارة كروس أوفر كهربائية مدمجة أُطلقت مؤخراً في الأسواق.
وبحسب بيانات منفصلة صادرة عن شركة جاتو ديناميكس أمس، واصل المصنعون الصينيون تسجيل نمو قوي في السوق الأوروبية خلال مايو، حيث باعت الشركات الصينية 65808 سيارة كهربائية في 28 سوقاً أوروبية، لترتفع حصتها السوقية إلى 5.9%، مقارنة بـ 2.9% في الشهر نفسه من العام الماضي.

تابعوا آخر أخبار بوابة الوفد الإلكترونية عبر نبض
تابعوا آخر أخبار بوابة الوفد الإلكترونية عبر نبض